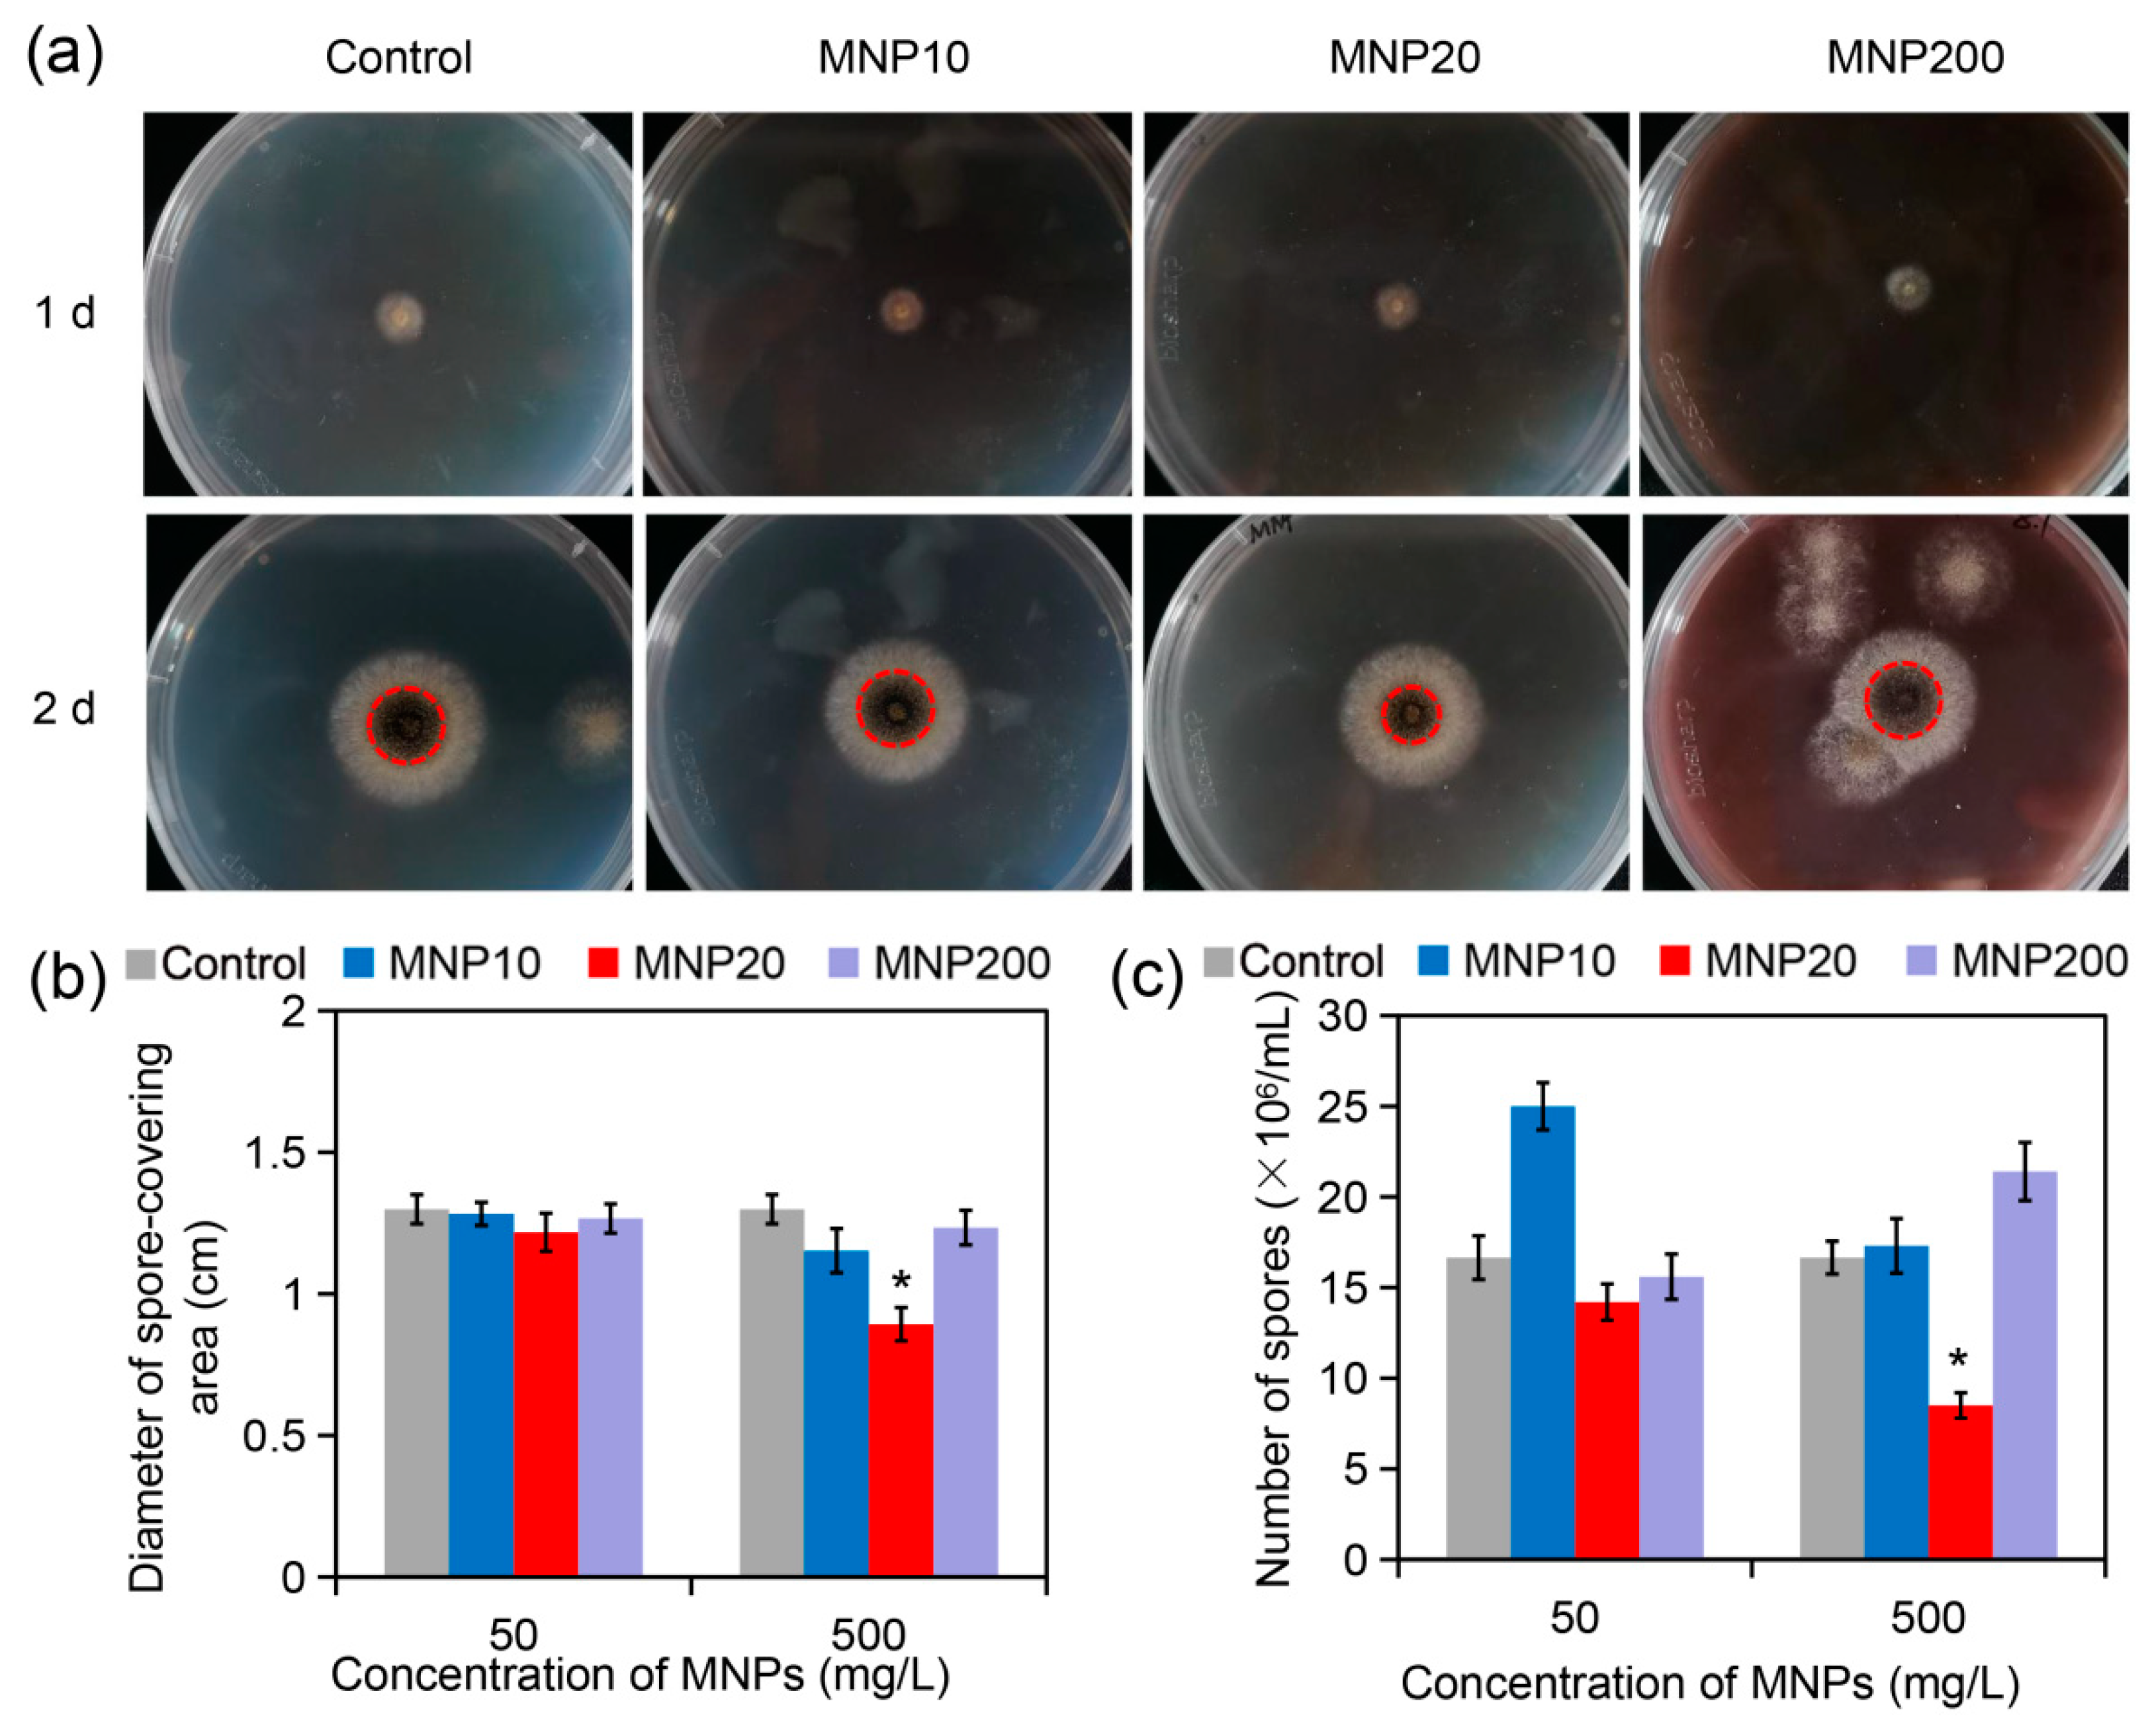
Molecules 27 05840 g002

Size-Dependent Impact of Magnetic Nanoparticles on Growth and Sporulation of Aspergillus niger
Abstract
:1. Introduction
2. Results and Discussion
2.1. Characterization of the Synthesized MNPs with Different Sizes
2.2. Impact of the MNPs on A. niger Growth and Sporulation
2.3. Cell Wall Disruption Induced by MNP20
2.4. Effect of Iron Dissolution from MNPs on Sporulation
2.5. Effect of ROS Accumulation during MNP Treatment on Sporulation
3. Materials and Methods
3.1. Materials
3.2. Methods
3.2.1. Strains and Growth Conditions
3.2.2. Preparation and Characterization of Fe3O4 Nanoparticles with Different Particle Sizes
3.2.3. Growth Inhibition Assays and Measurement of Spore Production Capacity
3.2.4. Cell Wall Staining
3.2.5. Chitin Measurement
3.2.6. β-1,3-Glucan Assay
3.2.7. Statistical Analysis
4. Conclusions
Supplementary Materials
Author Contributions
Funding
Institutional Review Board Statement
Informed Consent Statement
Data Availability Statement
Acknowledgments
Conflicts of Interest
References
- Thambugala, K.M.; Daranagama, D.A.; Phillips, A.J.L.; Kannangara, S.D.; Promputtha, I. Fungi vs. fungi in biocontrol: An overview of fungal antagonists applied against fungal plant pathogens. Front. Cell. Infect. Microbiol. 2020, 10, 604923. [Google Scholar] [CrossRef]
- Krain, A.; Siupka, P. Fungal guttation, a source of bioactive compounds, and its ecological role—A review. Biomolecules 2021, 11, 1270. [Google Scholar] [CrossRef] [PubMed]
- Kapoor, R.T.; Salvadori, M.R.; Rafatullah, M.; Siddiqui, M.R.; Khan, M.A.; Alshareef, S.A. Exploration of microbial factories for synthesis of nanoparticles—A sustainable approach for bioremediation of environmental contaminants. Front. Microbiol. 2021, 12, 658294. [Google Scholar] [CrossRef] [PubMed]
- Yazici, A.; Ortucu, S.; Taskin, M. Screening and characterization of a novel antibiofilm polypeptide derived from filamentous fungi. J. Proteom. 2021, 233, 104075. [Google Scholar] [CrossRef] [PubMed]
- Sun, X.; Su, X. Harnessing the knowledge of protein secretion for enhanced protein production in filamentous fungi. World J. Microbiol. Biotechnol. 2019, 35, 54. [Google Scholar] [CrossRef]
- Park, H.S.; Jun, S.C.; Han, K.H.; Hong, S.B.; Yu, J.H. Diversity, application, and synthetic biology of industrially important Aspergillus fungi. Adv. Appl. Microbiol. 2017, 100, 161–202. [Google Scholar] [PubMed]
- Chroumpi, T.; Makela, M.R.; de Vries, R.P. Engineering of primary carbon metabolism in filamentous fungi. Biotechnol. Adv. 2020, 43, 107551. [Google Scholar] [CrossRef]
- Olempska-Beer, Z.S.; Merker, R.I.; Ditto, M.D.; DiNovi, M.J. Food-processing enzymes from recombinant microorganisms—A review. Regul. Toxicol. Pharmacol. 2006, 45, 144–158. [Google Scholar] [CrossRef]
- Li, C.; Zhou, J.; Du, G.; Chen, J.; Takahashi, S.; Liu, S. Developing Aspergillus niger as a cell factory for food enzyme production. Biotechnol. Adv. 2020, 44, 107630. [Google Scholar] [CrossRef]
- Frisvad, J.C.; Moller, L.L.H.; Larsen, T.O.; Kumar, R.; Arnau, J. Safety of the fungal workhorses of industrial biotechnology: Update on the mycotoxin and secondary metabolite potential of Aspergillus niger, Aspergillus oryzae, and Trichoderma reesei. Appl. Microbiol. Biotechnol. 2018, 102, 9481–9515. [Google Scholar] [CrossRef] [Green Version]
- Cairns, T.C.; Nai, C.; Meyer, V. How a fungus shapes biotechnology: 100 years of Aspergillus niger research. Fungal Biol. Biotechnol. 2018, 5, 13. [Google Scholar] [CrossRef] [PubMed]
- Lu, A.H.; Salabas, E.L.; Schuth, F. Magnetic nanoparticles: Synthesis, protection, functionalization, and application. Angew. Chem. Int. Ed. 2007, 46, 1222–1244. [Google Scholar] [CrossRef] [PubMed]
- Cardoso, V.F.; Francesko, A.; Ribeiro, C.; Banobre-Lopez, M.; Martins, P.; Lanceros-Mendez, S. Advances in magnetic nanoparticles for biomedical applications. Adv. Healthc. Mater. 2018, 7, 1700845. [Google Scholar] [CrossRef] [PubMed]
- Alagiri, M.; Muthamizhchelvan, C.; Ponnusamy, S. Structural and magnetic properties of iron, cobalt and nickel nanoparticles. Synth. Met. 2011, 161, 1776–1780. [Google Scholar] [CrossRef]
- Tang, C.; He, Z.; Liu, H.; Xu, Y.; Huang, H.; Yang, G.; Xiao, Z.; Li, S.; Liu, H.; Deng, Y.; et al. Application of magnetic nanoparticles in nucleic acid detection. J. Nanobiotechnol. 2020, 18, 62. [Google Scholar] [CrossRef]
- Sizikov, A.A.; Kharlamova, M.V.; Nikitin, M.P.; Nikitin, P.I.; Kolychev, E.L. Nonviral locally injected magnetic vectors for in vivo gene delivery: A review of studies on magnetofection. Nanomaterials 2021, 11, 1078. [Google Scholar] [CrossRef]
- Ma, Y.; Chen, T.; Iqbal, M.Z.; Yang, F.; Hampp, N.; Wu, A.; Luo, L. Applications of magnetic materials separation in biological nanomedicine. Electrophoresis 2019, 40, 2011–2028. [Google Scholar] [CrossRef]
- Li, X.; Li, W.; Wang, M.; Liao, Z. Magnetic nanoparticles for cancer theranostics: Advances and prospects. J. Control. Release 2021, 335, 437–448. [Google Scholar] [CrossRef]
- Gawali, S.L.; Shelar, S.B.; Gupta, J.; Barick, K.C.; Hassan, P.A. Immobilization of protein on Fe3O4 nanoparticles for magnetic hyperthermia application. Int. J. Biol. Macromol. 2021, 166, 851–860. [Google Scholar] [CrossRef]
- Du, W.; Liu, T.; Xue, F.; Cai, X.; Chen, Q.; Zheng, Y.; Chen, H. Fe3O4 mesocrystals with distinctive magnetothermal and nanoenzyme activity enabling self-reinforcing synergistic cancer therapy. ACS Appl. Mater. Interfaces 2020, 12, 19285–19294. [Google Scholar] [CrossRef] [PubMed]
- Mukherjee, S.; Liang, L.; Veiseh, O. Recent advancements of magnetic nanomaterials in cancer therapy. Pharmaceutics 2020, 12, 147. [Google Scholar] [CrossRef] [PubMed]
- Vakili-Ghartavol, R.; Momtazi-Borojeni, A.A.; Vakili-Ghartavol, Z.; Aiyelabegan, H.T.; Jaafari, M.R.; Rezayat, S.M.; Arbabi Bidgoli, S. Toxicity assessment of superparamagnetic iron oxide nanoparticles in different tissues. Artif. Cells Nanomed. Biotechnol. 2020, 48, 443–451. [Google Scholar] [CrossRef] [PubMed]
- Wei, H.; Hu, Y.; Wang, J.; Gao, X.; Qian, X.; Tang, M. Superparamagnetic iron oxide nanoparticles: Cytotoxicity, metabolism, and cellular behavior in biomedicine applications. Int. J. Nanomed. 2021, 16, 6097–6113. [Google Scholar] [CrossRef] [PubMed]
- Huang, C.-C.; Liao, Z.-X.; Lu, H.-M.; Pan, W.-Y.; Wan, W.-L.; Chen, C.-C.; Sung, H.-W. Cellular organelle-dependent cytotoxicity of iron oxide nanoparticles and its implications for cancer diagnosis and treatment: A mechanistic investigation. Chem. Mater. 2016, 28, 9017–9025. [Google Scholar] [CrossRef]
- Yarjanli, Z.; Ghaedi, K.; Esmaeili, A.; Rahgozar, S.; Zarrabi, A. Iron oxide nanoparticles may damage to the neural tissue through iron accumulation, oxidative stress, and protein aggregation. BMC Neurosci. 2017, 18, 51. [Google Scholar] [CrossRef]
- Jarockyte, G.; Daugelaite, E.; Stasys, M.; Statkute, U.; Poderys, V.; Tseng, T.C.; Hsu, S.H.; Karabanovas, V.; Rotomskis, R. Accumulation and toxicity of superparamagnetic iron oxide nanoparticles in cells and experimental animals. Int. J. Mol. Sci. 2016, 17, 1193. [Google Scholar] [CrossRef]
- Peng, Q.; Huo, D.; Li, H.; Zhang, B.; Li, Y.; Liang, A.; Wang, H.; Yu, Q.; Li, M. ROS-independent toxicity of Fe3O4 nanoparticles to yeast cells: Involvement of mitochondrial dysfunction. Chem. Biol. Interact. 2018, 287, 20–26. [Google Scholar] [CrossRef]
- Adams, T.H.; Wieser, J.K.; Yu, J.H. Asexual sporulation in Aspergillus nidulans. Microbiol. Mol. Biol. Rev. 1998, 62, 35–54. [Google Scholar] [CrossRef]
- Amelia Piñón Castillo, H.; Nayzzel Muñoz Castellanos, L.; Martínez Chamorro, R.; Reyes Martínez, R.; Orrantia Borunda, E. Nanoparticles as new therapeutic agents against Candida Albicans. In Candida Albicans; Sandai, D., Ed.; IntechOpen: London, UK, 2018; Chapter 7. [Google Scholar]
- Ren, T.; Zheng, X.; Bai, R.; Yang, Y.; Jian, L. Utilization of PLGA nanoparticles in yeast cell wall particle system for oral targeted delivery of exenatide to improve its hypoglycemic efficacy. Int. J. Pharm. 2021, 601, 120583. [Google Scholar] [CrossRef]
- Sacks, D.; Baxter, B.; Campbell, B.C.V.; Carpenter, J.S.; Cognard, C.; Dippel, D.; Eesa, M.; Fischer, U.; Hausegger, K.; Hirsch, J.A.; et al. Multisociety consensus quality improvement revised consensus statement for endovascular therapy of acute ischemic stroke. Int. J. Stroke 2018, 13, 612–632. [Google Scholar] [CrossRef] [Green Version]
- Xie, M.; Yang, J.; Jiang, K.; Bai, N.; Zhu, M.; Zhu, Y.; Zhang, K.Q.; Yang, J. AoBck1 and AoMkk1 are necessary to maintain cell wall integrity, vegetative growth, conidiation, stress resistance, and pathogenicity in the nematode-trapping fungus Arthrobotrys oligospora. Front. Microbiol. 2021, 12, 649582. [Google Scholar] [CrossRef] [PubMed]
- Hu, Y.; Zhang, H.R.; Dong, L.; Xu, M.R.; Zhang, L.; Ding, W.P.; Zhang, J.Q.; Lin, J.; Zhang, Y.J.; Qiu, B.S.; et al. Enhancing tumor chemotherapy and overcoming drug resistance through autophagy-mediated intracellular dissolution of zinc oxide nanoparticles. Nanoscale 2019, 11, 11789–11807. [Google Scholar] [CrossRef] [PubMed]
- Liao, C.; Jin, Y.; Li, Y.; Tjong, S.C. Interactions of zinc oxide nanostructures with mammalian cells: Cytotoxicity and photocatalytic toxicity. Int. J. Mol. Sci. 2020, 21, 6305. [Google Scholar] [CrossRef]
- Wang, Z.; Xiao, P.; He, N. Synthesis and characteristics of carbon encapsulated magnetic nanoparticles produced by a hydrothermal reaction. Carbon 2006, 44, 3277–3284. [Google Scholar] [CrossRef]
- Hoch, H.C.; Galvani, C.D.; Szarowski, D.H.; Turner, J.N. Two new fluorescent dyes applicable for visualization of fungal cell walls. Mycologia 2005, 97, 580–588. [Google Scholar] [CrossRef] [PubMed]
- Futagami, T.; Seto, K.; Kajiwara, Y.; Takashita, H.; Omori, T.; Takegawa, K.; Goto, M. The putative stress sensor protein MtlA is required for conidia formation, cell wall stress tolerance, and cell wall integrity in Aspergillus nidulans. Biosci. Biotechnol. Biochem. 2014, 78, 326–335. [Google Scholar] [CrossRef]
- Sosa-Acosta, J.R.; Iriarte-Mesa, C.; Ortega, G.A.; Díaz-García, A.M. DNA-iron oxide nanoparticles conjugates: Functional magnetic nanoplatforms in biomedical applications. Top. Curr. Chem. 2020, 378, 13. [Google Scholar] [CrossRef]

Publisher’s Note: MDPI stays neutral with regard to jurisdictional claims in published maps and institutional affiliations. |
© 2022 by the authors. Licensee MDPI, Basel, Switzerland. This article is an open access article distributed under the terms and conditions of the Creative Commons Attribution (CC BY) license (https://creativecommons.org/licenses/by/4.0/).
Share and Cite
Shi, Z.; Zhao, Y.; Liu, S.; Wang, Y.; Yu, Q. Size-Dependent Impact of Magnetic Nanoparticles on Growth and Sporulation of Aspergillus niger. Molecules 2022, 27, 5840. https://doi.org/10.3390/molecules27185840
Shi Z, Zhao Y, Liu S, Wang Y, Yu Q. Size-Dependent Impact of Magnetic Nanoparticles on Growth and Sporulation of Aspergillus niger. Molecules. 2022; 27(18):5840. https://doi.org/10.3390/molecules27185840
Chicago/Turabian StyleShi, Zhishang, Yan Zhao, Shuo Liu, Yanting Wang, and Qilin Yu. 2022. "Size-Dependent Impact of Magnetic Nanoparticles on Growth and Sporulation of Aspergillus niger" Molecules 27, no. 18: 5840. https://doi.org/10.3390/molecules27185840
APA StyleShi, Z., Zhao, Y., Liu, S., Wang, Y., & Yu, Q. (2022). Size-Dependent Impact of Magnetic Nanoparticles on Growth and Sporulation of Aspergillus niger. Molecules, 27(18), 5840. https://doi.org/10.3390/molecules27185840

